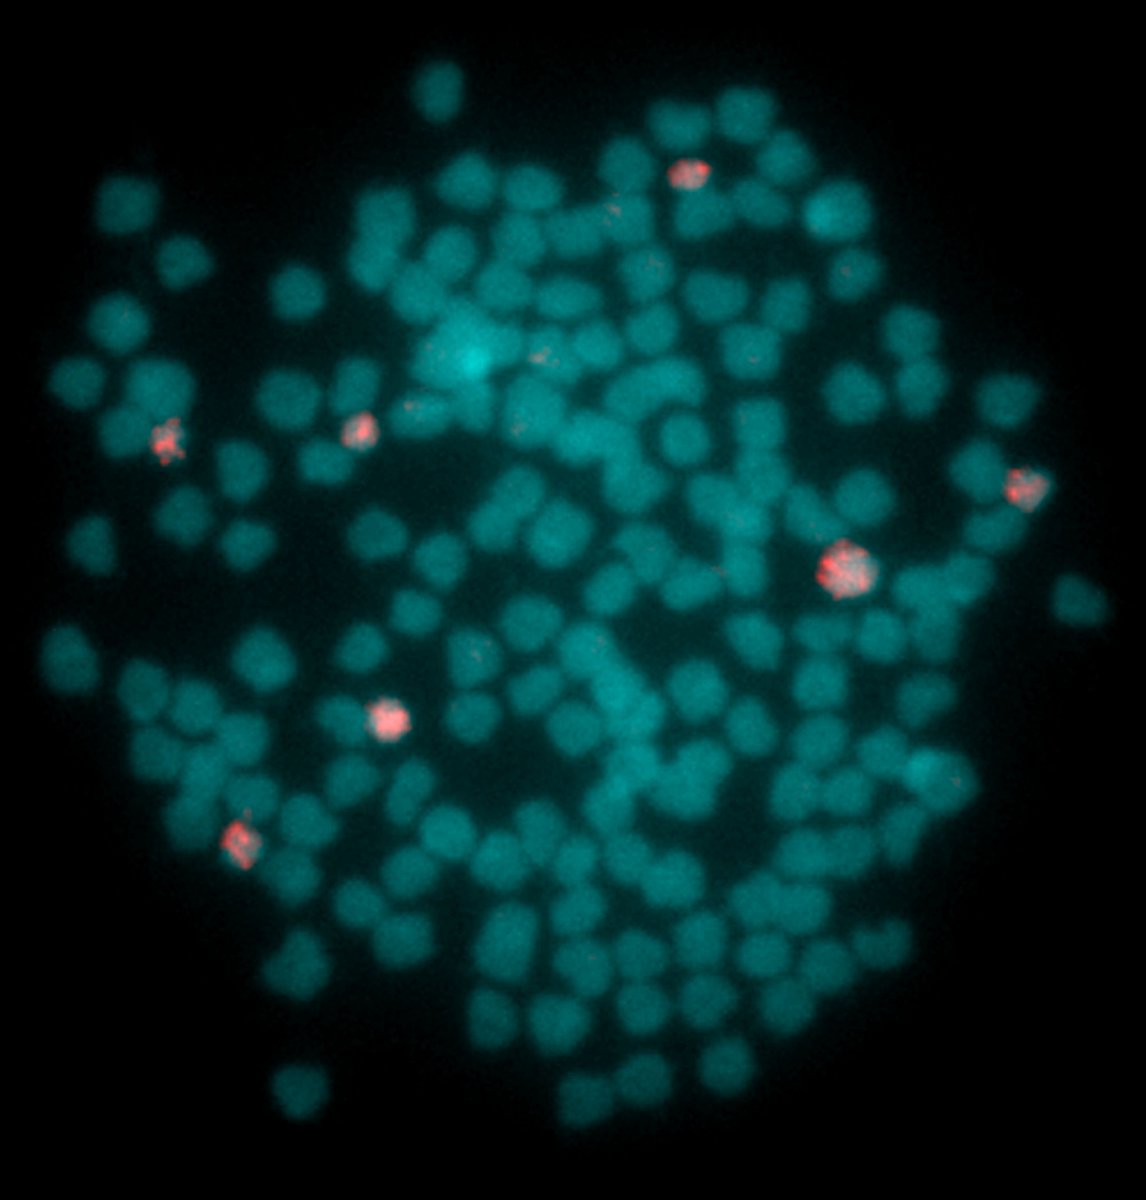
Cytogenetic Analysis of the Fish Genus Carassius Indicates Divergence, Fission, and Segmental Duplication as Drivers of Tandem Repeat and Microchromosome Evolution buff.ly/3InQl1M <a href="/KnytlMartin/">Martin Knytl</a> <a href="/ReiForna/">Nicola Reinaldo Fornaini</a> #science #evolution #biology #genome

Nicola Reinaldo Fornaini
@reiforna
Biologist
PhD student at Charles University
Frogs enjoyer 🐸
ID: 1638488417297223680
22-03-2023 10:31:17
21 Tweet
22 Followers
71 Following

Tetraploidy in the Boettger’s dwarf clawed frog (Pipidae: Hymenochirus boettgeri) from the Congo indicates non-conspecificity with the captive population academic.oup.com/zoolinnean/art… Martin Knytl

Finally I'm sharing all of my previous papers :D Measurement of Chromosomal Arms and FISH Reveal Complex Genome Architecture and Standardized Karyotype of Model Fish, Genus Carassius mdpi.com/1261692 #mdpicells via Cells MDPI




I'm proud to share the paper we recently published. Thanks to my supervisor Martin Knytl. Cytogenetic analysis of the fish genus Carassius indicates divergence, fission and segmental duplication as drivers of tandem repeat and microchromosome evolution academic.oup.com/gbe/article/do…

Cytogenetic Analysis of the Fish Genus Carassius Indicates Divergence, Fission, and Segmental Duplication as Drivers of Tandem Repeat and Microchromosome Evolution buff.ly/3InQl1M Martin Knytl Nicola Reinaldo Fornaini #science #evolution #biology #genome

Today we students from Martin Knytl group presented a poster at #JCSevocellbio conference in Catalunya. We are proud to be there, it was an amazing experience!



Just wrapped up our V4SDB Summer School and it was an amazing experience! Big shoutout to Peter Walentek, Alice Reis, BuchtovaLab, Máté Varga, Cellular Imaging Core Facility - CEITEC, V4SDB, Masarykova univerzita, The Company of Biologists for making it unforgettable! 🐸🐟🐔 #PhDtraining #Xenopus #Zebrafish #Chicken



‼️At the extraordinary election meeting of the Academic Senate of the Faculty of Science Charles University on 24 October 2024, the candidate for Dean was elected doc. Vladimír Krylov. natur.cuni.cz/en/news/5533-a…


The 14th DevCell Biology PhD Conference at Faculty of Science of Charles University is at full swing.






